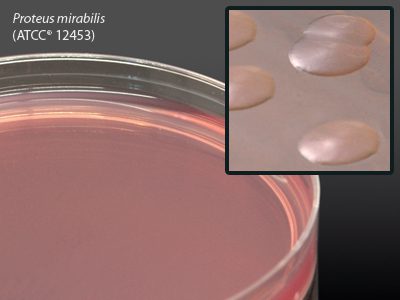

Bioreagents
Tryptic Soy Broth (TSB) with Lecithin and Tween, Hardy Diagnostics – U134G, Tryptic Soy Broth (TSB) with Lecithin and Tween 80
$104.89TSB USP WITH LECITHIN & TWEEN 90 ML FILL
Puritan ESK Environmental Sampling Kit, with Neutralizing Buffer, Sterile, Hardy Diagnostics – 2583010PDBNB, Neutralizing Buffer Swabs, with Polystyrene Handle & Polyester Tip
$631.05ENVIRONMENTAL SAMPLING KIT STERILE 10 ML
CARBOL FUCHSIN 8OZ F/ACID FAST BACTERIA – CF008, 8 oz.
$30.04CARBOL FUCHSIN 8OZ F/ACID FAST BACTERIA
BRILLIANT GREEN COUNTERSTAIN 1%W/V 250ML – BG008, 250 ml
$20.60BRILLIANT GREEN COUNTERSTAIN 1%W/V 250ML
Phosphate Buffer, Hardy Diagnostics – U192, Phosphate Buffer
$309.22PHOSPHATE BUFFER PH6.8 0.067M 1L PC BTL
Phosphate Buffered Saline (PBS), Hardy Diagnostics – K163, Phosphate Buffered Saline (PBS)
$111.26PHOSPHATE BUFFERED SALINE PH 7.5 9.9 ML
Neutralizing Buffered Peptone Water, Hardy Diagnostics – C9242, CRITERION Neutralizing Buffered Peptone Water Dehydrated Culture Media
$280.28PEPTONE WATER NEUTRALIZING BUFFERED 2 KG
Neutralizing Buffered Peptone Water, Hardy Diagnostics – C9241, CRITERION Neutralizing Buffered Peptone Water Dehydrated Culture Media
$77.61PEPTONE WATER NEUTRALIZING BUFFERED 500G
Neutralizing Buffered Peptone Water, Hardy Diagnostics – C9240, CRITERION Neutralizing Buffered Peptone Water Dehydrated Culture Media
$47.46PEPTONE WATER NEUTRALIZING BUFFERED 2 L
HardyCHROM Candida, CRITERION, Hardy Diagnostics – C9000, HardyCHROM Candida, CRITERION
$135.57MEDIUM HARDYCHROM CANDIDA CULTURE 2 L
Alpha Biosciences Barney Miller Agar, Hardy Diagnostics – B02125, Prepared media plate
$281.60AGAR BARNEY MILLER SELECTIVE MEDIUM 500G